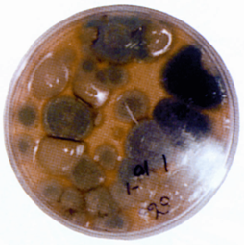

السموم والتسمم في الدواجن
تلعب السموم دورا مهما في صحة الدواجن فتؤدي بكثير من المشاريع الانتاجية الى خسائر اقتصادية في الانتاج وزيادة التكاليف في العلاج والتحصينات وبالتالي يحصل المربي على عائد غير مجزي. والسموم تنتشر في الغالب في قطعان الدواجن بشكل كبير نظرا للتربية المكثفة ولطبيعة تركيب العلائق في الدواجن والتي تحتوي على عناصر قابلة وبشكل كبير للإصابة بالسموم الفطرية.
علم السموم
هو العلم المختص بدراسة ما يتعلق بالمواد السامة، مثل مصادر السموم وخواصها الفيزيائية والكيميائية، وطرق الكشف عن السموم وأعراض التسمم وطرق العلاج، وتحديد الجرعات السامة المميتة من السموم ودراسة مسار السموم داخل الجسم.
كيفية حدوث التسمم:
يحدث التسمم للأسباب التالية:
1- تناول جرعات عالية من الأدوية.
2- تناول الدواجن للنباتات السامة الطبيعية أو الملوثة بالمبيدات أو العلائق الملوثة بسم بعض الفطريات.
3- تناول الدواجن للمياه الملوثة.
4- تعرض الدواجن لسموم الثعابين والعقارب.
امتصاص السموم:
يحدث التأثير السام للسموم بعد امتصاصها ووصولها للدم وتدخل هذه السموم للجسم عن طريق (الفم أو الرئتين عن طريق الشم أو الحقن).
السموم الداخلة عن طريق الفم للأمعاء تمتص من الغشاء المخاطي للأمعاء أما السموم الداخلة عن طريق التنفس للرئتين، فتمتص عن طريق الحويصلات الهوائية بالرئتين، مثل ثاني أكسيد الكربون ورابع كلوريد الكربون والكلوروفورم، وتمتص بعض السموم بسهولة عن طريق الأغشية المخاطية للعين والفم وكذلك الجروح المفتوحة.

شكل (1) أضرار الفطريات وسمومها في الأعلاف
شكل (2) بعض النموات الفطرية علي مادة غذائية داخل طبق (بتري)

شكل (3) السموم الفطرية أحد أخطر مصادر التسمم للأعلاف وخاصة الذرة
انتشار السموم:
السموم الممتصة تصل عن طريق الدم إلى الكبد. والكبد هو العضو المسؤول عن التخلص من السموم. ثم تنتشر من الكبد إلى بقية أجزاء الجسم. وبعض السموم تختزن في أنسجة الجسم الأخرى مثل الفلورين والرصاص في العظام واليود في الغدة الدرقية.
إخراج السموم :
أغلب السموم يتم إخراجها عن طريق الكليتين وبعض السموم تخرج عن طريق الرئتين، مثل السموم الغازية وبعضها عن طريق القناة الهضمية في الذرق أو عن طريق الغدد الإخراجية في اللعاب.
أنواع السموم
السموم عديدة ولها تقسيمات تبعا لعدة عوامل، ولكن سنكتفي بأخذ تقسيماتها الهامة وأهمها التقسيم حسب مصدرها:
أ- السموم غير العضوية
1- الأحماض المركزة - حمض الكبريتيك والنيتريك.
2- القلويات المركزة – هيدروكسيد الصوديوم وهيدروكسيد الأمونيا.
3- الأملاح المعدنية – أملاح الرصاص وأملاح الزرنيخ وملح الطعام.
4- اللافلزات – الكلور والفلور.
ب- السموم العضوية
1- سموم نباتية مثل الإستركنين والمورفين والديجوكسين.
2- سموم حيوانية مثل سم الثعابين والعقارب.
3- سموم كيميائية مثل رابع كلوريد الكربون ومركبات السلفا والكحول المثيلي والكلوروفورم وكذلك بعض السموم الفطرية مثل (الأفلاتوكسين والأوكراتوكسين).
الأعراض العامة المميزة للتسمم
قبل موت الحيوان:
1- الأعراض العامة مثل الخمول والانعزال والتمدد على الأرض.
2- التشنجات العضلية والعصبية والإنهاك.
3- في الكتاكيت: نجد انسداد لفتحة المجمع.
بعد موت الحيوان:
1- تلون الأغشية المخاطية ب
أ- اللون الأصفر- تسمم بالفوسفور.
ب- اللون الأزرق - تسمم بأول أكسيد الكربون
ج- اللون البني - تسمم بالنترات والنيتريت.
2- وجود بذور وبقايا بعض النباتات السامة في أمعاء الحيوان.
3- وجود تهتكات والتهابات في الأمعاء كالتسمم بالأحماض الكيميائية.
4- وجود أنزفه بالعضلات والأعضاء الداخلية.
5- بالتحليل الكيميائي لبعض العينات مثل (اللعاب، البول، البراز، الكبد، القلب، الدهون، الأعلاف) يمكن اكتشاف المسبب.
القواعد العامة لعلاج حالات التسمم:
كل حالة تسمم تحتاج لعلاج خاص بها، ولكن هناك قواعد عامة لعلاج حالات التسمم ومنها:
أولا : تفريغ السم الممتص عن طريق الفم:
أ- الغسيل المعدي للحويصلة: باستعمال الماء أو محلول الترياق.
تنبيه:
لا يستعمل الأنبوب المعدي في حالة التسمم بالأحماض والقلويات المركزة لمنع حدوث نزيف أو قيء في المعدة أو المريء.
ب- إعطاء المسهلات.
ج- ضبط درجة الحرارة والرطوبة.
تنبيه:
يجب سحب مسحوق الحليب إذا كان داخل في مكونات العليقة وذلك لكونه يساعد في سرعة امتصاص السموم خصوصا الفسفور والسموم القلوية.
ثانيا: السموم الممتصة عن طريق الدم
السموم التي وصلت للدم يتم الإسراع في إخراجها عن طريق:
أ- الكليتان
بإعطاء مدرات البول مثل المحلول الفسيولوجي أو محلول الجلوكوز.
ب- الغدد العرقية (للأنواع الأخرى من الحيوانات)
بإعطاء المعرقات (Diaphoretics) مثل البيلوكاربين Pilocarbin والطيور لا يوجد لديها غدد عرقية وعلاج الطيور المصابة بالتسمم لا فائدة منه في أغلب الحالات ولكن قد نلجأ للعلاج للقطعان الصغيرة.
ثالثا: إعطاء الترياقات:
الترياق: هو مادة تعمل على إيقاف أو عمل السم أو إبطاله فتمنع امتصاصه أو تغير خواصه أو تضاد تأثيره السمي.
أنواع الترياقات هناك نوعان من الترياقات:
١- الترياق الفيزيائي:
وهو المادة التي تؤدي إلى إبطال عمل السم بطريقة فيزيائية مثل الفحم النباتي والمواد المبطنة مثل الدهون والنشأ التي تعمل على حماية الأغشية المخاطية وكذلك المخففات مثل الماء.
٢- الترياق الكيميائي:
وهو الذي يؤدي إلى إبطال عمل السم بتكوين مركبات غير ذائبة (قليلة الامتصاص) أو قليلة السمية عن طريق بعض التفاعلات الكيميائية كالقلويات المخففة مثل أكسيد الماغنيسيوم أو الترياقات المرسبة مثل (حامض التانيك) Tannic acid في حالات التسمم المعدي بالرصاص والنحاس.
السموم الفطرية في أعلاف الدواجن
وهي مركبات بيوكيميائية تفرزها أنواع معينة من الفطريات أثناء عملية التمثيل الغذائي الخاصة بهذه الفطريات:
ومنها عدة أنواع وهي الأكثر سمية للدواجن:
١- الأفلاتوكسين
٢- الأوكراتوكسين
٣- الفوزاریوتوكسين
4- ستريتين
وغالبا ما تتواجد تلك السموم في الأعلاف (العلائق الجاهزة) للدواجن.
أثارها على الطائر:
1- اختلال وظائف الكبد والكلى والبنكرياس
۲- تقرحات داخل تجويف الفم
٣- انخفاض الجهاز المناعي للطائر
أعراضها في الدواجن
١- خمول وانخفاض استهلاك العلف
۲- حدوث إسهالات مختلفة اللون.
الوقاية منها:
1- تتم الوقاية منها بالحفاظ على الأعلاف في أماكن جيدة التهوية وغير رطبة.
۲- تحليل الأعلاف مختبريا قبل تقديمها للطيور للتأكد من خلوها من الأفلاتوكسين والسموم.
3- إضافة مضادات السموم الفطرية للأعلاف حسب التوصيات للشركات المنتجة مثل المضاد توكسنيل بمعدل 1-3 كجم /طن علف أو الاتجاه الحديث بإضافة مضاد التسمم الفطري الماء الشرب مثل مستحضر السيتروكس بمعدل تخفيف 0.5 سم/ 1 لتر لماء الشرب وحسب العمر لمدة 12 ساعة وحتى زوال الأعراض وتوقف النفوق.